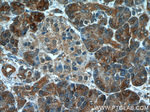
NUBP2 Antibody in Immunohistochemistry (Paraffin) (IHC (P))

Search
Proteintech
NUBP2 Polyclonal Antibody
{{$productOrderCtrl.translations['antibody.pdp.commerceCard.promotion.promotions']}}
{{$productOrderCtrl.translations['antibody.pdp.commerceCard.promotion.viewpromo']}}
{{$productOrderCtrl.translations['antibody.pdp.commerceCard.promotion.promocode']}}: {{promo.promoCode}} {{promo.promoTitle}} {{promo.promoDescription}}. {{$productOrderCtrl.translations['antibody.pdp.commerceCard.promotion.learnmore']}}
产品信息
15409-1-AP
种属反应
宿主/亚型
分类
类型
抗原
偶联物
形式
浓度
规格
纯化类型
保存液
内含物
保存条件
运输条件
产品详细信息
Immunogen sequence: MEAAAEPGN LAGVRHIILV LSGKGGVGKS TISTELALAL RHAGKKVGIL DVDLCGPSIP RMLGAQGRAV HQCDRGWAPV FLDREQSISL MSVGFLLEKP DEAVVWRGPK KNALIKQFVS DVAWGELDYL VVDTPPGTSD EHMATIEALR PYQPLGALVV TTPQAVSVGD VRRELTFCRK TGLRVMGIVE NMSGFTCPHC TECTSVFSRG GGEELAQLAG VPFLGSVPLD PALMRTLEEG HDFIQEFPGS PAFAALTSIA QKILDATPAC LP (1-271 aa encoded by BC002768)
仅用于科研。不用于诊断过程。未经明确授权不得转售。
生物信息学
蛋白别名: Cytosolic Fe-S cluster assembly factor NUBP2; cytosolic Fe-S cluster assembly factor NUBP2 {ECO:0000255|HAMAP-Rule:MF_03039}; homolog of yeast cytosolic Fe-S cluster deficient 1; NBP 2; NBP 2 {ECO:0000255|HAMAP-Rule:MF_03039}; nucleotide binding protein 2 (MinD homolog, E. coli); Nucleotide-binding protein 2; nucleotide-binding protein 2 {ECO:0000255|HAMAP-Rule:MF_03039}; unnamed protein product
基因别名: CFD1; CIAO6; D17Wsu11e; NBP 2; NUBP1; NUBP2
UniProt ID: (Human) Q9Y5Y2, (Mouse) Q9R061, (Rat) Q68FS1
Entrez Gene ID: (Human) 10101, (Mouse) 26426, (Rat) 287125